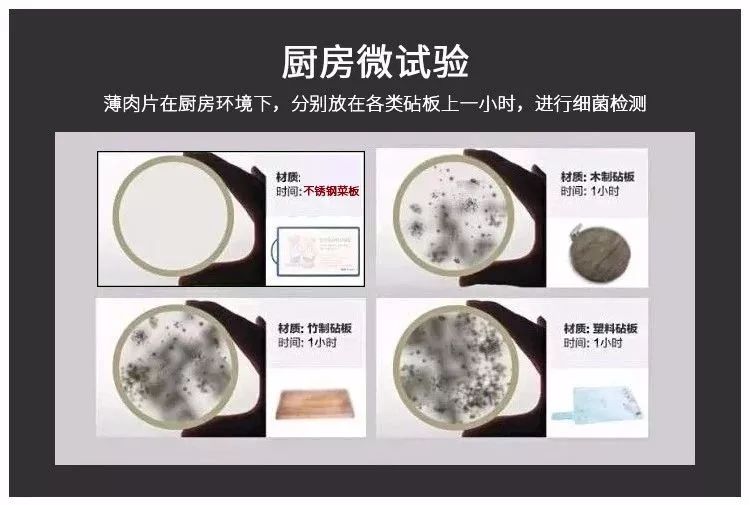
一冲一擦就干净如新,一冲就干净

点击上方申江服务导报,跟着小申吃喝玩乐逛上海
一说起『Made in Germany』也就是“德国制造”,大家都觉得不错~
他们的严谨,也是全世界出了名的。
因为德国企业的员工遵守标准就像驾驶员遵守红绿灯一样自然。

部分德国品牌
像汽车工人都经过至少3年半“学徒制”的专业培训,仅拧各种螺丝就要学习几个月。

“开上一次德国车,你可能一辈子都开德国车。”
这句话成为德国汽车的代言,成为了汽车制造业的标杆。
大到汽车,小到一个镜头、一块手表、一个剃须刀,处处都力求极致,对每个生产细节都精益求精。

有一种厨房叫德国厨房。
有人说:用德国的锅具,一根蜡烛就能做一顿佳肴。
只要你看过德国人的厨房,你会觉得他们做的不是饭菜,而是生活的品质!

厨房里的每个锅,每把刀都让人觉得是艺术品。
其中,有着140年历史的巴本豪森,是90%以上的德国家庭都爱用的顶级厨具品牌。

巴本豪森所有的产品,均采用符合欧盟标准的食品级合金基材,并所有产品都通过了世界各大权威机构的检测,质量、安全令人信服。

用过的人都说:用过巴本豪森的菜板,20年都不想再用其他菜板了。

能让这么人在众多菜板选中它
一定有过人之处:
1、防霉防菌,新鲜食材健康加工;
2、食品级不锈钢材质,安全无异味;
3、抛光防滑处理,不钝刀不刺耳。
很多妈咪都在推荐它!

一块巴本豪森菜板,有了它,不仅仅只是加工食材,更是对生活的一种独到见解和热爱。


每个家庭都有一块砧板,一用就是好几年,你们可知,看似干净的砧板,早已伤痕累累。
每条刀痕都塞满了食物残渣,且厨房潮湿,洗得再干净,也已经被污染了。

北京卫视健康节目做过实验,在新菜板剁肉30秒,静置一小时,竟滋生了82毫克/c㎡的细菌。

意味着连续使用3个月的菜板,会滋生大肠菌群、霉菌、沙氏门菌、粪球菌等多达2亿个/c㎡,比马桶脏200倍!

而巴本豪森菜板采用了防霉防菌的天然金属CU元素,均匀分布在菜板结构内,大大降低细菌的滋生,简单来说就是用上20年都不会发霉,发臭。

肉片分别放置在不锈钢菜板、木质、竹制、塑料的菜板1小时,通过显微镜观察的细菌含量分别如下:
特别是对黄曲霉素、大肠杆菌等常见病菌进行检测,菌丝生长等级为0.23,说明就算在潮湿天气,这块砧板都不会发霉、滋生细菌。

有了它,妈妈给宝宝做辅食,每天不重样,宝宝不挑食,吃得开心,妈妈也放心。


我们一般给菜板消毒都是烧开水烫,可是市面上大多数木制胶制的菜板,用开水烫根本是无法完全杀死病毒细菌的,而且像胶制的菜板,一旦温度稍高就会释放三聚氰胺、相当于每天在吃甲醛。

巴本豪森菜板选用了食品级304不锈钢,可以直接与食物接触,具有耐用、耐腐蚀、耐高温800℃、防霉抗菌、去异味的性能。

不起沫、不掉屑,不隐藏食物残渣。

有些不良商家,用普通不锈钢冒充,非常不道德,因为普通不锈钢在使用时,重金属的迁移量会超标。
因此家里有不锈钢厨具的,最好用识别水鉴别,不变色的是食品级,非食品级会产生反应留下颜色。
下图是巴本豪森菜板和其他菜板的检测结果。

并经过3次的专业检测,持续煮沸30分钟并放置24小时,重金属迁移量符合国家规定,证实了巴本豪森菜板是食品级,安全的!

每份经过它加工的食材,像是经过德国技术精准计算,每一片肉的厚度都恰到好处,每一口的味道,都堪比米其林餐厅的高级料理。

且当不锈钢合金与空气、水分子接触发生触媒作用,释放出铁离子将异味分子结构分解,“还原”成原始无味状态。

家里不锈钢菜刀切什么都不会粘上味道、不锈钢肥皂去异味,也是这个原理。

切了肉再切水果,再也不会出现水果吃出肉味的恶心感了。


它厚度是2.09毫米,比起几十厘米的普通砧板,它存放不占空间,就算搬家也方便携带。

经过拉丝抛光等十几项工艺,表面更有质感,更防滑,切山药和鱼也不怕滑溜溜的,不会切到手。

逢过年过节,包饺子妈妈都直接在台面揉面擀面,不干净不卫生,有了它,揉面不沾,方便操作,每一片饺子皮都薄弹俱佳。

大家应该都会担心是否毁刀,食品级304不锈钢比菜刀硬度更低,只要不当仇人砍,基本不会伤刀。

一冲就干净,不像普通菜板还要拿钢丝球刷,用牙签剔陷在刀痕的肉渣。

边角打磨处理,圆润不伤手,便携提手设计,拿起、挂上都很方便。

当然,它也有一个小小的缺点,就是切菜的时候,发出的声音比木质砧板要大那么一丢丢。
小编测试过,切硬番茄发出的声音保持在50分贝,而正常说话的声音是在40~60分贝,因此切菜不会十分刺耳。

四种型号,任君选择!


没有差评,99%的回购率!
“比较干净,更加健康”
“很好洗,不滋生细菌”
“寿命长久,性价比高”

一桌的美味饭菜,少不了一块好砧板,全家人的健康,离不开我们的精心呵护。
没错它比满大街随手能买到的菜板贵不少,但是严谨精湛的德国工艺,它贵,但它值!
每个幸福的家庭都应该有一块能保证健康的菜板,这才生活该有的烟火气。
低至58元,错过即恢复108元起!

点击下图“小程序”即可购买
《申》报热销商品




